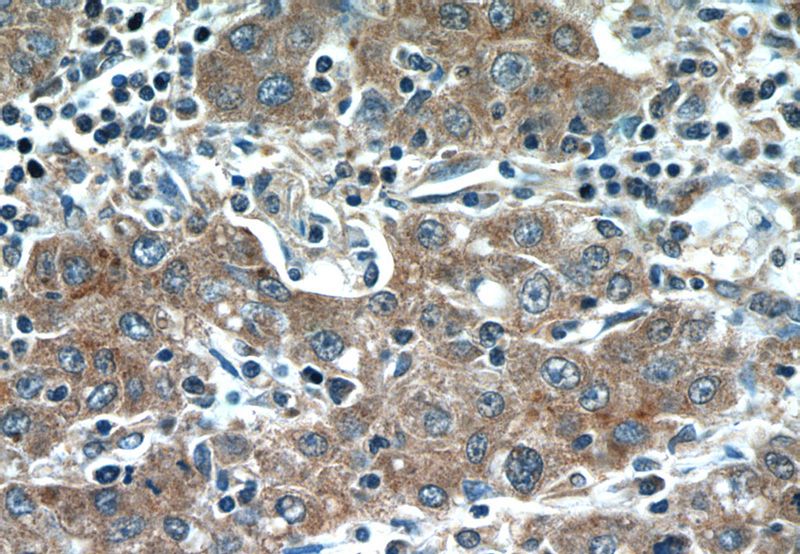
Immunohistochemistry of paraffin-embedded human liver cancer tissue slide using Catalog No:111088(GPC3 Antibody) at dilution of 1:50 (under 40x lens)

-
Product Name
Glypican 3 antibody
- Documents
-
Description
Glypican 3 Rabbit Polyclonal antibody. Positive WB detected in HepG2 cells. Positive IF detected in HEK-293 cells. Positive IHC detected in human liver cancer tissue. Observed molecular weight by Western-blot: 66 kDa
-
Tested applications
ELISA, IHC, WB, IF
-
Species reactivity
Human; other species not tested.
-
Alternative names
DGSX antibody; Glypican 3 antibody; GPC3 antibody; GTR2 2 antibody; Intestinal protein OCI 5 antibody; MXR7 antibody; OCI 5 antibody; OCI5 antibody; SDYS antibody; SGB antibody; SGBS antibody; SGBS1 antibody
-
Isotype
Rabbit IgG
-
Preparation
This antibody was obtained by immunization of Glypican 3 recombinant protein (Accession Number: NM_004484). Purification method: Antigen affinity purified.
-
Clonality
Polyclonal
-
Formulation
PBS with 0.1% sodium azide and 50% glycerol pH 7.3.
-
Storage instructions
Store at -20℃. DO NOT ALIQUOT
-
Applications
Recommended Dilution:
WB: 1:200-1:2000
IHC: 1:20-1:200
IF: 1:20-1:200
-
Validations

HepG2 cells were subjected to SDS PAGE followed by western blot with Catalog No:111088(GPC3 Antibody) at dilution of 1:600

Immunohistochemistry of paraffin-embedded human liver cancer tissue slide using Catalog No:111088(GPC3 Antibody) at dilution of 1:50 (under 10x lens)
Immunohistochemistry of paraffin-embedded human liver cancer tissue slide using Catalog No:111088(GPC3 Antibody) at dilution of 1:50 (under 40x lens)

Immunofluorescent analysis of HEK-293 cells using Catalog No:111088(GPC3 Antibody) at dilution of 1:50 and Alexa Fluor 488-congugated AffiniPure Goat Anti-Rabbit IgG(H+L)
-
Background
Glypicans (GPCs) are a family of glycosylphosphatidylinositol (GPI)-anchored heparan sulphate proteoglycans (HSPGs) that may play a role in the control of cell division and growth regulation. In mammals, there are six GPCs (GPC1 to GPC6), all of which have a similar core-protein size of approx. 60 kDa and the clustering of glycosaminoglycan attachment site near the C-terminus. They are tethered to the cell surface by GPI linkages, which can be cleaved by endogenous phospholipases, thus releasing the protein. Glypican 3 (GPC3) is highly expressed in many tissues during development and plays an important role in the regulation of embryonic growth (PMID: 22467855). Loss-of-function mutations of GPC3 result in the Simpson-Golabi-Behmel overgrowth syndrome (SGBS), and Gpc-3 null mice display developmental overgrowth (PMID: 8589713; 18477453). In hepatocellular carcinoma (HCC), the overexpression of GPC3 has been demonstrated to be a reliable diagnostic indicator (PMID: 19212669; 22706665).
Related Products / Services
Please note: All products are "FOR RESEARCH USE ONLY AND ARE NOT INTENDED FOR DIAGNOSTIC OR THERAPEUTIC USE"
